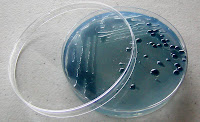

Autoclave- Aparelho utilizado para esterilizar equipamentos e reagentes.
Balança- Normalmente no laboratório é electrónica e de precisão.
Balão- Instrumento de vidro para efectuar misturas ou reacções químicas.
Centrifugadora- Aparelho utilizado em laboratório para separar fases de uma mistura (fases líquidas e sólidas).Centrifugadora- Aparelho utilizado em laboratório para separar fases de uma mistura (fases líquidas e sólidas).
Destilador- Equipamento utilizado para a destilação de água em laboratório.
Espectrómetro- Aparelho utilizado em investigação para
determinar as características de determinada substância com o objectivo
de a identificar. Este apaelho utiliza um feixe luminoso e mede
comprimentos de onda.
Funil- Empregado para transferir líquidos e para apoiar o papel de filtro.
Goblé- Ou copo de percepitação. Parecido com um copo de vidro mas resistente ao calor e à corrosão. Tem uma escala pouco precisa
Lâmina e Lamela- A lâmina é um rectângulo, normalmente de
vidro, utilizado para a "montagem da amostra" para observação ao
microscópio. É por cima da lâmina que se coloca a amostra. A Lamela (ou lamínula) é uma fina placa de vidro, ou de outro material, que se coloca por cima da amostra que se quer observar no microscópio.
Microscópio- É um aparelho utilizado para visualizar micro
estruturas. Estas micro-estruturas podem ser amostras de tecido
animal/vegetal como na imagem. Há microscópios que aumentam a amostra em
500000x.
![]() |
| Células da casca da cebola vista ao microscópio |
![]() |
| Células do sangue vistas ao microscópio |
Pipeta- Uma pipeta é o nome genérico dado a um
instrumento bastante comum no laboratório de análises. Este instrumento
pode ser de vidro ou plástico, ter uma escala mais ou menos precisa,
pode ser manual ou mecânico e serve para medir volumes de líquidos.
Placa de Petri- Um placa de Petri é uma caixa de vidro ou plástico redonda e achatada, que é usada para crescer culturas de microorganismos.
Pompete- Uma pompete é uma bomba de borracha com 3 vias de entrada/ saída de ar
Rolha- Tal como a rolha de cortiça utilizada nas garrafas, uma
rolha num laboratório tem exactamente a mesma função. Uma rolha de
laboratório pode ser de varias materiais, cortiça, vidro, silicone,
etc.
Sequenciador- Sequenciador genético é um equipamento utilizado
para sequenciar o material genético, com o objectivo de conhecer a
posição das bases e assim conseguir identificar genes.
Termómetro- é idêntico aos antigos termómetros de mercúrio que
utilizávamos em casa, mas a escala é maior, consoante a necessidade de
medição do estudo que se leva a cabo. Também há termómetros
electrónicos, estes são mais precisos, pois os primeiros dependem do
observador.
Tubo- Os tubos de ensaio são recipientes normalmente de vidro alongados e cilíndricos, são muito utilizados em experiências com pouco volume.
Vareta de Vidro- Vara em vidro que serve para homogeneizar soluções e entre outras coisas, decantar misturas manualmente.
Et voilá!
O equipamento certo faz um bom cientista!
Divirtam-se!

Sem comentários:
Enviar um comentário